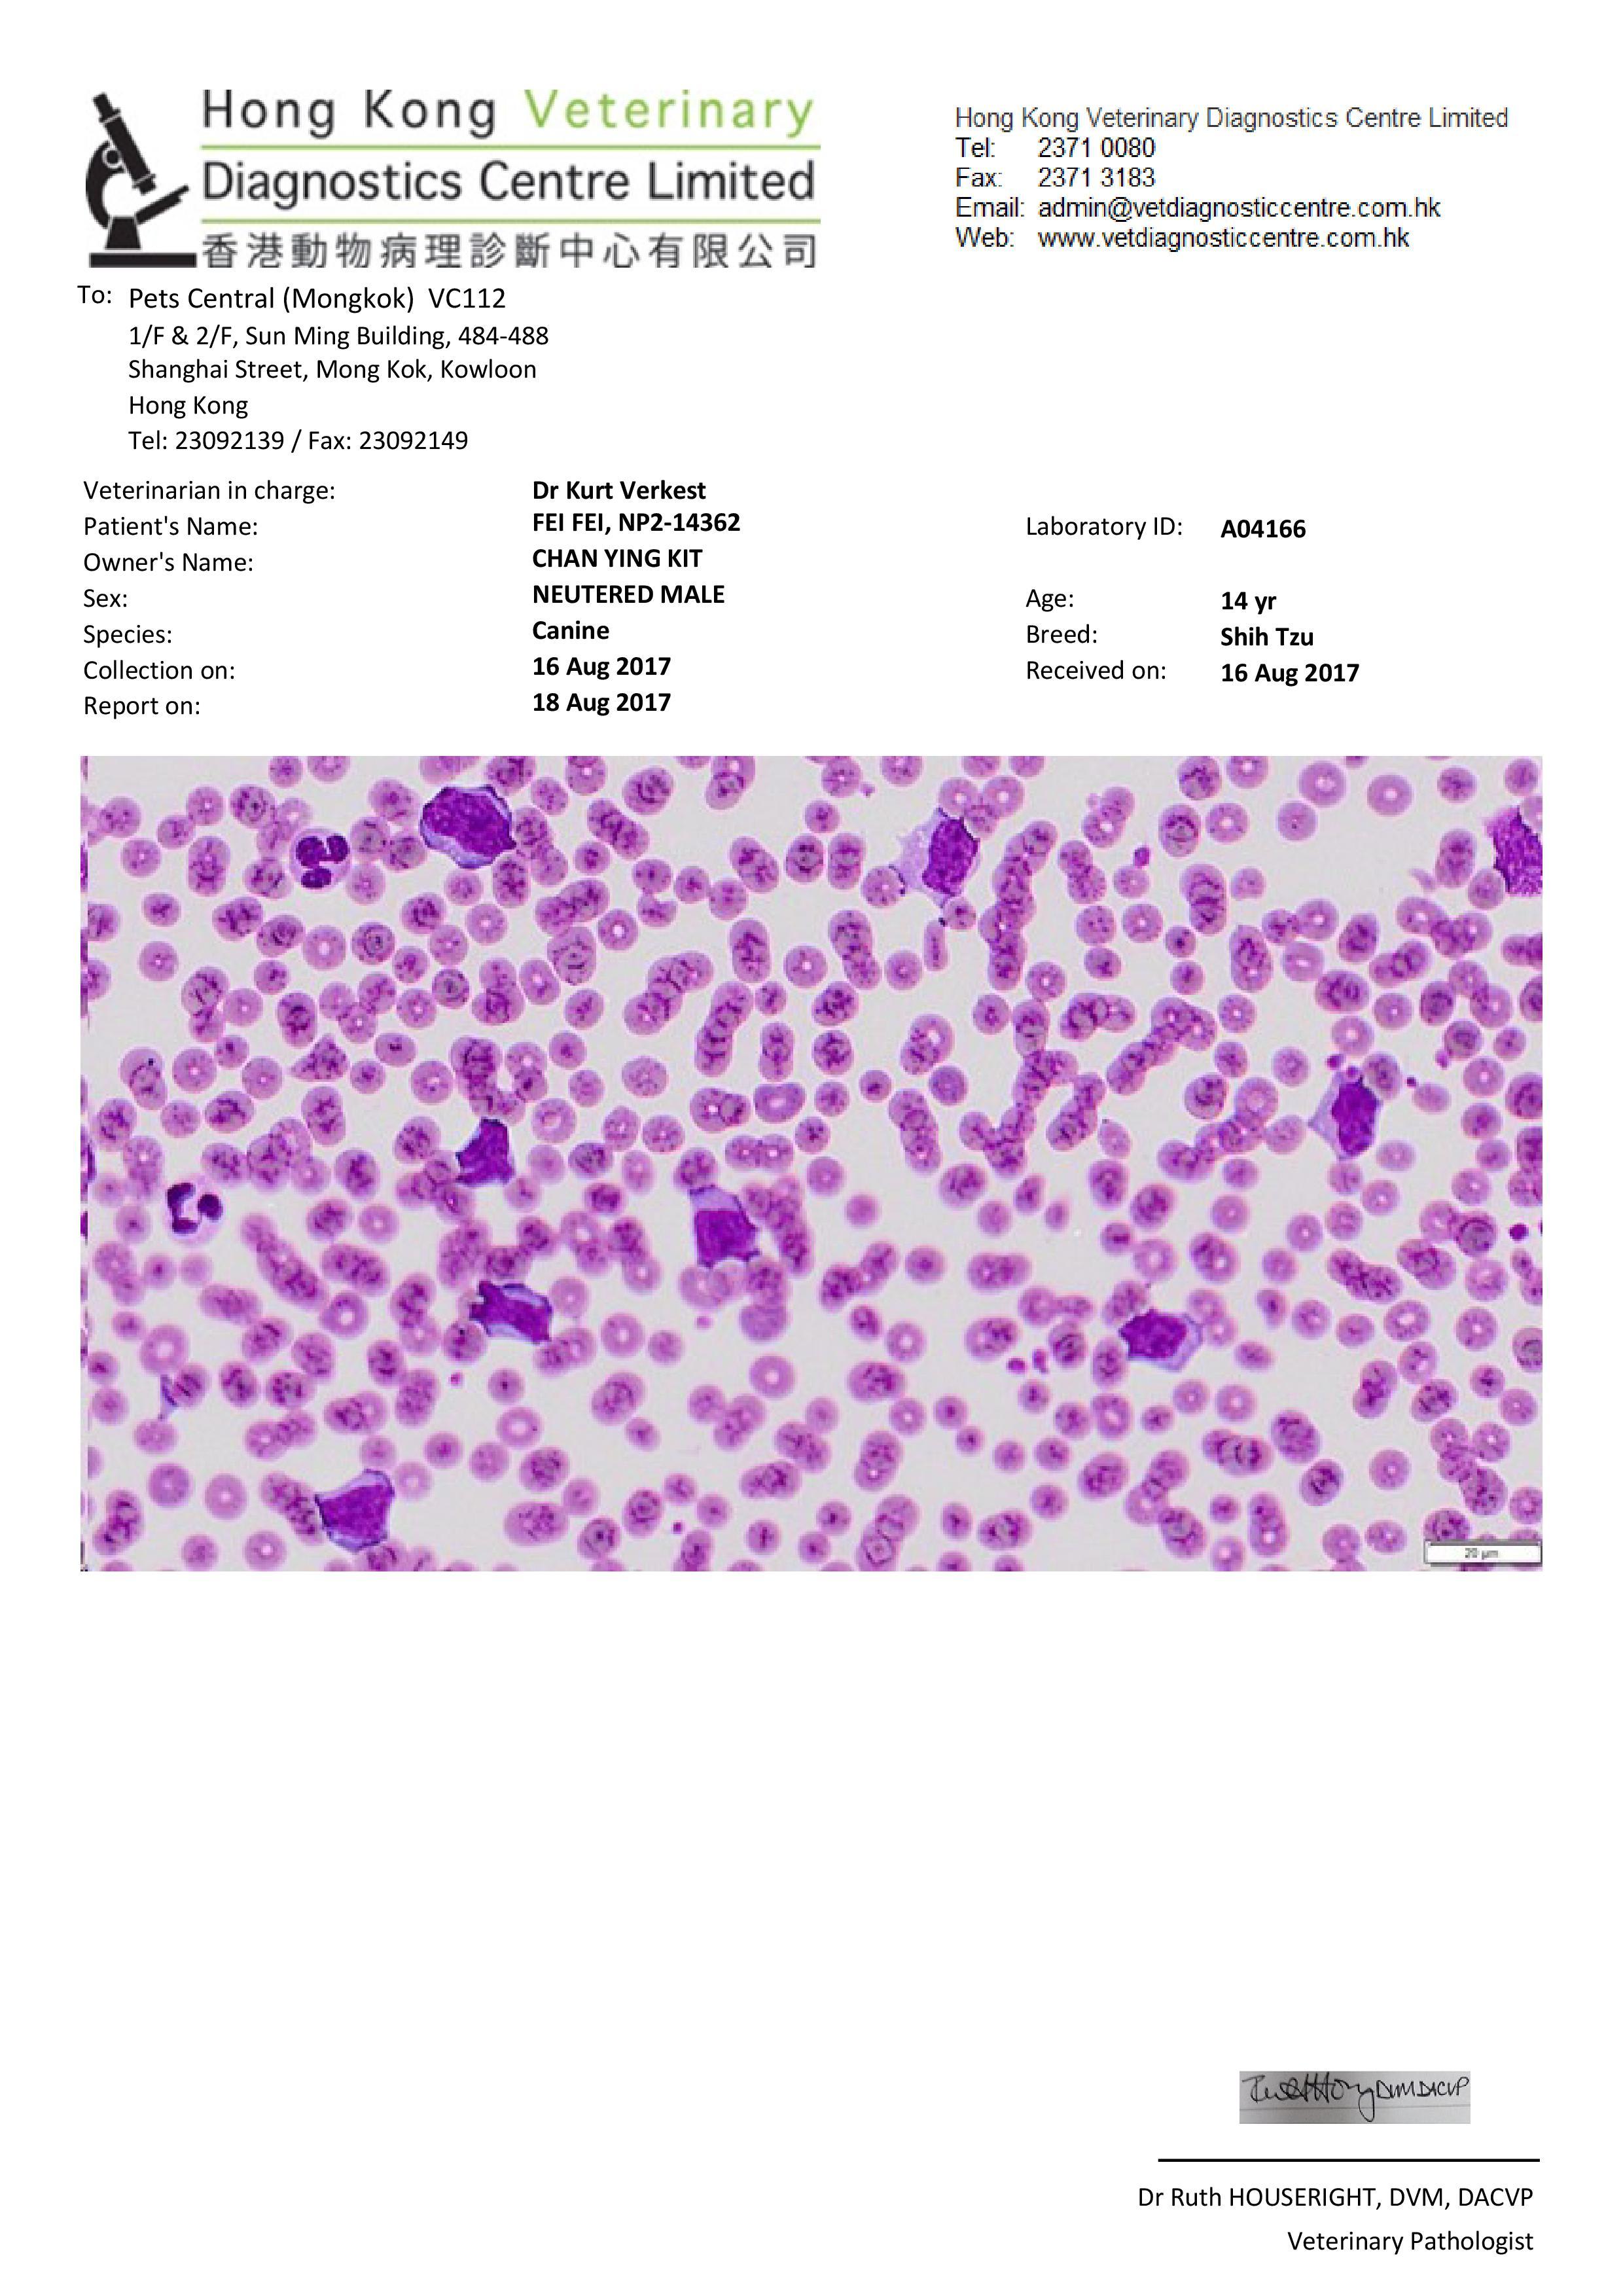
Question details sensitive content

Should I continue chemo for my senior dog with lymphoma? Prognosis?
Updated On September 23rd, 2025
Pet's info: Dog | Shih Tzu | Male | neutered | 14 years and 2 months old | 18 lbs
Hi, My dog (14) just diagnosed with Stage V lymphoma and cutaneous lymphoma. He is received Chemo for 2 dose. How is the prognosis or remission rate ? Should I continue? Thanks! Andy

1 Answer
Most Helpful Answer
Published on August 18th, 2017
In my experience lymphoma is a cancer that responds well to chemotherapy. Generally the lymph nodes shrink quickly and the dogs quality of life improves while in remission. Due to your dog's age and stage of cancer you may not get a long period of remission but Fei Fei should feel well during that time. So if you are seeing improvement in his clinical signs I would continue the recommended chemotherapy protocol. Remember to enjoy everyday with Fei Fei. Thanks for using Petco Pet Education Center, formerly Petcoach to get answers to your veterinary questions.
1Pet Parents found this answer helpful

Book an appointment with the pros – our expert vets are here to help.






